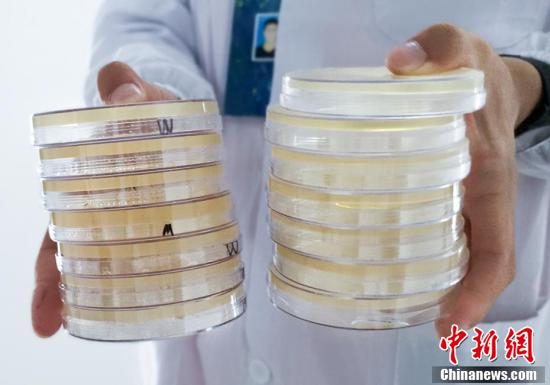

The creative process was extremely demanding. Students had to consider not only the growth and the color matching of bacterial colonies, but also the way the culture medium was used.(Photo/Jiang Chen)
 |
 Fire brigade in Shanghai holds group wedding
Fire brigade in Shanghai holds group wedding Tourists enjoy ice sculptures in Datan Town, north China
Tourists enjoy ice sculptures in Datan Town, north China Sunset scenery of Dayan Pagoda in Xi'an
Sunset scenery of Dayan Pagoda in Xi'an Tourists have fun at scenic spot in Nanlong Town, NW China
Tourists have fun at scenic spot in Nanlong Town, NW China Harbin attracts tourists by making best use of ice in winter
Harbin attracts tourists by making best use of ice in winter In pics: FIS Alpine Ski Women's World Cup Slalom
In pics: FIS Alpine Ski Women's World Cup Slalom Black-necked cranes rest at reservoir in Lhunzhub County, Lhasa
Black-necked cranes rest at reservoir in Lhunzhub County, Lhasa China's FAST telescope will be available to foreign scientists in April
China's FAST telescope will be available to foreign scientists in April "She power" plays indispensable role in poverty alleviation
"She power" plays indispensable role in poverty alleviation Top 10 world news events of People's Daily in 2020
Top 10 world news events of People's Daily in 2020 Top 10 China news events of People's Daily in 2020
Top 10 China news events of People's Daily in 2020 Top 10 media buzzwords of 2020
Top 10 media buzzwords of 2020 Year-ender:10 major tourism stories of 2020
Year-ender:10 major tourism stories of 2020 No interference in Venezuelan issues
No interference in Venezuelan issues
 Biz prepares for trade spat
Biz prepares for trade spat
 Broadcasting Continent
Broadcasting Continent Australia wins Chinese CEOs as US loses
Australia wins Chinese CEOs as US loses